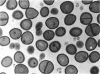
1039

Abstract
The growth and viability of Staphylococcus aureus, Escherichia coli, and Pseudomonas aeruginosa exposed to various concentrations of a number of β-lactam group antibiotics were determined. In S. aureus, the bacteriolytic and bactericidal activity of these drugs was lower at very high drug concentrations than that occurring at low concentrations, but these phenomena were not observed in E. coli and P. aeruginosa. Under phase-contrast and scanning electron microscopy, S. aureus treated with high concentrations of β-lactam group antibiotics revealed a lower frequency of bacteriolysis than at low drug concentrations, and similarly by transmission electron microscopy fewer cells were transformed into spheroplasts at high drug concentrations. However, swelling of the cell wall septum was seen in many cells. Spheroplast formation occurred with the highest frequency at drug levels near the minimum inhibitory concentration and became less frequent as drug concentrations were increased.
Full text
PDF









Images in this article
Selected References
These references are in PubMed. This may not be the complete list of references from this article.
- Forsberg C., Rogers H. J. Autolytic enzymes in growth of bacteria. Nature. 1971 Jan 22;229(5282):272–273. doi: 10.1038/229272a0. [DOI] [PubMed] [Google Scholar]
- Hartmann R., Höltje J. V., Schwarz U. Targets of penicillin action in Escherichia coli. Nature. 1972 Feb 25;235(5339):426–429. doi: 10.1038/235426a0. [DOI] [PubMed] [Google Scholar]
- Horridge G. A., Tamm S. L. Critical point drying for scanning electron microscopic sthdy of ciliary motion. Science. 1969 Feb 21;163(3869):817–818. doi: 10.1126/science.163.3869.817. [DOI] [PubMed] [Google Scholar]
- Izumikawa K., Saito A., Nasu M., Hara K. [Respiratory infections treated with massive intravenous infasion of cephalothin (CET)]. Jpn J Antibiot. 1973 Feb;26(1):17–23. [PubMed] [Google Scholar]
- KELLENBERGER E., RYTER A., SECHAUD J. Electron microscope study of DNA-containing plasms. II. Vegetative and mature phage DNA as compared with normal bacterial nucleoids in different physiological states. J Biophys Biochem Cytol. 1958 Nov 25;4(6):671–678. doi: 10.1083/jcb.4.6.671. [DOI] [PMC free article] [PubMed] [Google Scholar]
- LEE C. C., HERR E. B., Jr, ANDERSON R. C. Pharmacological and toxicological studies on cephalotin. Clin Med (Northfield) 1963 Jun;70:1123–1138. [PubMed] [Google Scholar]
- LUFT J. H. Improvements in epoxy resin embedding methods. J Biophys Biochem Cytol. 1961 Feb;9:409–414. doi: 10.1083/jcb.9.2.409. [DOI] [PMC free article] [PubMed] [Google Scholar]
- MURRAY R. G., FRANCOMBE W. H., MAYALL B. H. The effect of penicillin on the structure of staphylococcal cell walls. Can J Microbiol. 1959 Dec;5:641–648. doi: 10.1139/m59-078. [DOI] [PubMed] [Google Scholar]
- Matsuhashi S., Kamiryo T., Blumberg P. M., Linnett P., Willoughby E., Strominger J. L. Mechanism of action and development of resistance to a new amidino penicillin. J Bacteriol. 1974 Feb;117(2):578–587. doi: 10.1128/jb.117.2.578-587.1974. [DOI] [PMC free article] [PubMed] [Google Scholar]
- Merrill S. L., Davis A., Smolens B., Finegold S. M. Cephalothin in serious bacterial infection. Ann Intern Med. 1966 Jan;64(1):1–12. doi: 10.7326/0003-4819-64-1-1. [DOI] [PubMed] [Google Scholar]
- Nishino T. An electron microscopic study of antagonism between cephalexin and erythromycin in Staphylococcus aureus. Jpn J Microbiol. 1975 Feb;19(1):53–63. doi: 10.1111/j.1348-0421.1975.tb00847.x. [DOI] [PubMed] [Google Scholar]
- Nishino T., Nakazawa S. Morphological changes in Staphylococcus aureus and Escherichia coli exposed to cephalexin. Jpn J Microbiol. 1972 Mar;16(2):83–94. doi: 10.1111/j.1348-0421.1972.tb00633.x. [DOI] [PubMed] [Google Scholar]
- PRESTIDGE L. S., PARDEE A. B. Induction of bacterial lysis by penicillin. J Bacteriol. 1957 Jul;74(1):48–59. doi: 10.1128/jb.74.1.48-59.1957. [DOI] [PMC free article] [PubMed] [Google Scholar]
- Perkins R. L., Saslaw S. Experiences with cephalothin. Ann Intern Med. 1966 Jan;64(1):13–24. doi: 10.7326/0003-4819-64-1-13. [DOI] [PubMed] [Google Scholar]
- REYNOLDS E. S. The use of lead citrate at high pH as an electron-opaque stain in electron microscopy. J Cell Biol. 1963 Apr;17:208–212. doi: 10.1083/jcb.17.1.208. [DOI] [PMC free article] [PubMed] [Google Scholar]
- Rogers H. J., Forsberg C. W. Role of autolysins in the killing of bacteria by some bactericidal antibiotics. J Bacteriol. 1971 Dec;108(3):1235–1243. doi: 10.1128/jb.108.3.1235-1243.1971. [DOI] [PMC free article] [PubMed] [Google Scholar]
- Schuhardt V. T., Klesius P. H. Osmotic fragility and viability of lysostaphin-induced staphylococcal spheroplasts. J Bacteriol. 1968 Sep;96(3):734–737. doi: 10.1128/jb.96.3.734-737.1968. [DOI] [PMC free article] [PubMed] [Google Scholar]
- Schwarz U., Asmus A., Frank H. Autolytic enzymes and cell division of Escherichia coli. J Mol Biol. 1969 May 14;41(3):419–429. doi: 10.1016/0022-2836(69)90285-x. [DOI] [PubMed] [Google Scholar]
- Shockman G. D. Symposium on the fine structure and replication of bacteria and their parts. IV. Unbalanced cell-wall synthesis: autolysis and cell-wall thickening. Bacteriol Rev. 1965 Sep;29(3):345–358. doi: 10.1128/br.29.3.345-358.1965. [DOI] [PMC free article] [PubMed] [Google Scholar]
- Spratt B. G., Pardee A. B. Penicillin-binding proteins and cell shape in E. coli. Nature. 1975 Apr 10;254(5500):516–517. doi: 10.1038/254516a0. [DOI] [PubMed] [Google Scholar]
- Stille W., Uffelmann H. Untersuchung über den paradoxen bakteriziden Effekt von Penicillinen auf Enterokokken (Eagle-Effekt. Dtsch Med Wochenschr. 1973 Mar 23;98(12):611–613. doi: 10.1055/s-0028-1106868. [DOI] [PubMed] [Google Scholar]
- Tomasz A., Waks S. Mechanism of action of penicillin: triggering of the pneumococcal autolytic enzyme by inhibitors of cell wall synthesis. Proc Natl Acad Sci U S A. 1975 Oct;72(10):4162–4166. doi: 10.1073/pnas.72.10.4162. [DOI] [PMC free article] [PubMed] [Google Scholar]
- WEINSTEIN L., LERNER P. I., CHEW W. H. CLINICAL AND BACTERIOLOGIC STUDIES OF THE EFFECT OF "MASSIVE" DOSES OF PENICILLIN G ON INFECTIONS CAUSED BY GRAM-NEGATIVE BACILLI. N Engl J Med. 1964 Sep 10;271:525–533. doi: 10.1056/NEJM196409102711101. [DOI] [PubMed] [Google Scholar]